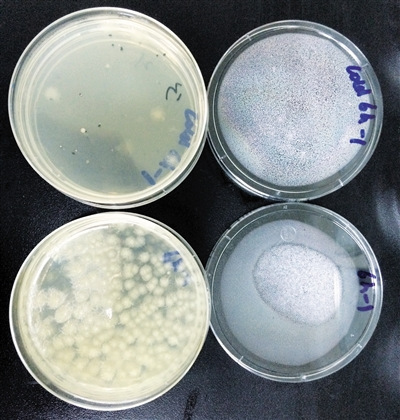
冷藏条件下样品(左)及常温下样品(右)中菌落总数对比明显。

鲜榨豆浆放4小时 就别给考生喝了
实验显示,半小时后常温下菌落为冷藏时6倍;常温放置6小时,豆浆中菌落总数增加近10倍

实验人员将豆浆取样,分别写上放置时间以备实验。记者 李婷婷 摄
眼看高考和中考的日子要到了,家长们都想着怎么给考生加强营养,甚至有的家长一大早起床榨好鲜豆浆,等着孩子起床后喝。然而,有传言称,“豆浆放半小时以上不能喝”,情况到底怎样?
记者在北京一家食品安全一级实验室,请实验人员模拟家中环境用豆浆机鲜榨豆浆,并测试在不同时间节点,在常温条件下和冷藏条件下,豆浆的菌落数量。
实验结果显示,鲜榨豆浆在常温下放置,半小时后菌落数量为210cfu/ml,2小时后为255cfu/ml,4小时后增长速度加快,到了6小时后飙升到2070cfu/ml。
相比于常温下,冷藏的鲜榨豆浆滋生的菌落数量明显较少。冷藏6小时后的豆浆菌落数量与常温下放置1小时后的豆浆中菌落数量相同。
中国农业大学食品科学与营养工程学院副教授朱毅指出,如果把鲜榨豆浆在室温下敞开放置,在慢慢冷却的过程中,空气中的细菌就会进入豆浆中滋生。
她建议,夏天做了鲜榨豆浆,最好现榨现喝。如果怕烫,可以用速冷容器迅速冷却豆浆,或者在豆浆冷却后,放在冰箱里密封保存,以防变质。
冷藏条件下样品(左)及常温下样品(右)中菌落总数对比明显。
[ 责任编辑:郭碧娟 ]
原稿件标题URL:
原稿件作者:
转载编辑:郭碧娟
原稿件来源:新京报